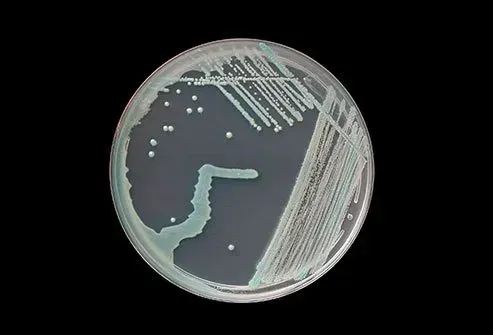

Les Informations Présentées Sur Ce Site Ne Constituent Pas Un Avis Médical. Nous Ne Vendons Rien. L'Exactitude De La Traduction N'Est Pas Garantie. Clause De Non-Responsabilité
MédicamentsInfections cutanées: types, causes et symptômes
Connaissez votre peau

Votre peau est votre première ligne de défense contre l'infection. Les nombreuses couches de peau offrent différents types de protection. La première couche connue sous le nom de l'épiderme est le bouclier de votre système immunitaire protégeant votre corps de l'assaut de virus de bactéries infectieuses parasites et champignons qui sont à proximité. La deuxième couche de peau, le derme soutient la surface de votre peau qui le fournit des nutriments et le rend plus difficile. La troisième et dernière couche de peau est la zone sous-cutanée. Il s'agit d'une couche de graisse qui agit comme un amortisseur maintient votre température stable et stocke l'énergie. Toutes vos couches cutanées fonctionnent ensemble pour éloigner les infections cutanées.
Comment votre peau est-elle infectée?

Une petite coupe est tout ce qu'il faut pour fournir une entrée de micro-organisme envahissante dans votre peau. C'est souvent ainsi qu'une infection cutanée prend racine. Parfois, la coupe n'est pas si petite après que vous ayez subi une intervention chirurgicale. Dans tous les cas, votre peau est plus vulnérable aux infections lorsqu'elle a été brisée d'une manière ou d'une autre.
Infections usually come from one of three main causes: bacteria viruses and fungi. Les levures et les parasites peuvent également les provoquer. Beaucoup d'entre eux sont inoffensifs à la surface de votre peau et de vos bactéries en particulier sont abondants sur toute la peau humaine. Mais quand ils entrent dans une rupture dans la peau, les problèmes peuvent commencer. Parfois, une rupture dans la peau n'est pas nécessaire et parfois un envahisseur de micro-organisme gagne dans le dessus parce que votre système immunitaire est faible ou est mal dirigé pour attaquer les mauvaises choses. Les causes des infections cutanées peuvent être complexes.
Comment les infections cutanées sont-elles traitées?

Pour les infections cutanées bactériennes, votre médecin peut prescrire des antibiotiques. Cependant, les bactéries résistantes aux antibactériennes sont devenues un problème croissant, en particulier dans les hôpitaux. Les infections cutanées fongiques peuvent être traitées avec des médicaments antifongiques également appelés agents antimycotiques. Il s'agit notamment des pilules et des crèmes dont certaines sont prescrites et dont certaines peuvent être achetées dans une pharmacie sans ordonnance. Pour les infections virales, votre médecin peut utiliser la médecine antivirale ou éliminer la croissance elle-même. Parfois, une infection cutanée disparaît naturellement sans intervention médicale.
SARM

SARM (methicillin resistant Staphylococcus aureus ) est un type d'infection à staphylocoque qui résiste aux antibiotiques typiques. Ces bactéries ont développé un gène appelé MECA qui empêche les antibiotiques standard comme la pénicilline et d'autres de se lier aux bactéries. Le SARM n'est pas plus nocif que toute autre infection staphylomique, sauf qu'elle ne peut pas être facilement traitée. La plupart des infections bactériennes du SARM se produisent dans les hôpitaux et les maisons de soins infirmiers où les patients malades et âgés sont particulièrement vulnérables à l'infection. Ces infections peuvent parfois être également acquises dans les écoles de tatouage et les casernes militaires.
Pouvez-vous tomber enceinte sur la saison
Cellulite (érysiplas)

Causée par une infection bactérienne La cellulite déclenche le gonflement et la sensibilité des rougeurs cutanées. Cela rend votre peau chaude et l'infection se propage rapidement. Certains décrivent la peau comme ayant les fossettes d'une peau d'orange. Certaines personnes ont une fièvre de confusion et des heures de rythme cardiaque anormalement rapides avant le développement des symptômes de la peau. It usually occurs on the arms or legs. Cela peut être une affection cutanée grave et peut entraîner une gangrène d'intoxication sanguine et d'autres conditions mortelles comme l'infection aux organes. Les médecins traitent la cellulite à l'aide d'antibiotiques.
Impétigo

Impétigo is a bacterial infection that sometimes invades the body through a break in the skin but sometimes it can set in without any skin break. It causes crusty sores mainly on the face and hands but can appear elsewhere. Children especially boys are most prone to impetigo. But sometimes adults can get it too. It's most common during the summer. Outbreaks are possible as infections can spread to many people. When there are many impetigo sores or in the case of an outbreak oral antibiotics are called for. In milder cases topical antibiotics may be used as treatment.
La lysine fonctionne-t-elle pour l'herpès génital
Bactéries mangeuses de chair (fasciite nécrosante)

La fasciite nécrosante communément appelée «bactéries mangeuses de chair» peut être causée par plusieurs types de bactéries différents. Il s'agit d'une affection cutanée grave car la photo incluse le montre clairement. Il résulte des infections suffisamment profondes pour pénétrer le fascia superficiel élastique votre couche de peau la plus profonde. Il commence généralement à partir d'une petite lésion telle qu'une morsure d'insectes ou une ébullition généralement dans les jambes ou les pieds. Il se transforme alors généralement en cellulite. Finalement, une telle infection toxifie le corps provoquant un épuisement et une désorientation élevés de fièvres. Les lésions tissulaires majeures suit et la mort des bactéries mangeuses de chair est un résultat courant, en particulier si la chirurgie n'est pas effectuée rapidement.
Folliculite

Les follicules pileux sont les pochettes de peau qui maintiennent vos racines de cheveux en place. Lorsqu'ils sont enflammés, l'état est appelé folliculite. Bactérie Virus Fungus Levure et les infections parasites peuvent la provoquer, bien qu'elles puissent également être causées par des cheveux bouclés récemment rasés. Parfois, les bacs à remous mal entretenus peuvent répandre les infections bactériennes dans une condition connue sous le nom de folliculite à bain à remous. Le traitement varie en fonction de la cause. Il disparaît souvent seul. Mais pour la folliculite chronique courante sur les fesses des hommes et des femmes, l'épilation au laser peut être la meilleure option de traitement.
Bouillons et curboucles

Comme la folliculite, une ébullition se développe à partir d'un follicule pileux irrité. Mais dans le cas d'une ébullition (également appelée «furoncle»), l'infection est beaucoup plus profonde s'étendant au tissu sous-cutané de la troisième couche de la peau. Lorsque plusieurs bouillons fusionnent, nous appelons la masse un carbuncle. Les carbuncles sont les plus courants à l'arrière du cou et les personnes atteintes de diabète sont les plus susceptibles de les obtenir. Les ébullitions ont tendance à se rompre et à s'écouler par elles-mêmes, mais elles peuvent être amadies avec l'application de la chaleur humide comme avec un trottoir chaud. Si cela échoue, les médecins ont plusieurs options de traitement, notamment la coupe et la vidange de l'ébullition et des antibiotiques oraux. Si vous avez des furoncles, il est intelligent de garder régulièrement vos mains propres car ces infections peuvent se propager si vous ne faites pas attention.
Herpès génital

Le virus qui provoque l'herpès génital HSV-2 se trouve généralement dans la zone anale / génitale mais pas toujours. Il s'agit d'une infection virale qui dure une vie dans votre corps. Il se développe généralement après des relations sexuelles avec un partenaire infecté. Les épidémies provoquent une sensation de démangeaisons ou de brûlures suivies par le développement de petites cloques rougeâtres pendant environ une semaine à une semaine et demie pendant lesquelles le virus est particulièrement contagieux. La première épidémie est généralement la pire. Entre les épidémies, l'herpès reste dans votre corps dans un état de repos. Il existe des médicaments antiviraux pour les épidémies graves, notamment l'aciclovir Valaciclovir et la famciclovir. Évitez le sexe pendant une épidémie. Si vous avez des relations sexuelles, informez votre partenaire à l'avance et assurez-vous d'utiliser un préservatif pour réduire vos chances de propager la maladie.
Effets secondaires de Zoloft chez les personnes âgées
Boutons froids

Le virus de l'herpès de type 1 est plus susceptible de se développer sur le visage, en particulier autour de vos lèvres. Il est extrêmement courant, en particulier dans les parties surpeuplées du monde, où la plupart des enfants l'ont à l'âge de 5 ans. L'infection initiale est souvent la pire et peut provoquer de la fièvre et de l'agitation. Il rend également les glandes lymphatiques grandes et tendres. Comme l'herpès oral HSV-2 est une infection à vie qui devient dormante entre les épidémies. De nouvelles épidémies peuvent être causées par des fluctuations hormonales de stress et une maladie - pourquoi elles sont parfois appelées «cloques de fièvre». Les épidémies disparaissent avec le temps et bien que douloureuses et potentiellement embarrassantes, elles ne causent généralement pas d'autres problèmes. Cependant, le virus peut être réparti à d'autres zones de votre corps lors d'une épidémie, alors gardez vos mains propres pour éviter que cela ne se produise. Si vous trouvez la nuisance des boutons de froid insupportable, demandez à votre médecin une ordonnance pour aider à contrôler les épidémies.
Varicelle

L'éruption des démangeaisons de poulet commence comme des bosses rouges et des taches qui se forment en cloques pleines de liquide transparent. Le liquide clair devient nuageux au fil du temps et finit par se tarir. Cela laisse les croûtes pour se former puis tomber. Il commence généralement sur votre torse et votre visage avant de se propager sur les jambes de bras et le cuir chevelu. Cela est vrai pour les enfants spécifiquement; Les adultes peuvent ne pas avoir une éruption cutanée ou il peut se développer d'une manière différente. À son apogée chaque année, cette infection virale a envoyé plus de 10000 enfants à l'hôpital avant l'introduction d'un vaccin en 1995. Avec 91% des très jeunes enfants vaccinés, le taux d'hospitalisation avait diminué de 93% en 2012 selon les données du CDC.
Verrues d'eau (molluscum contagiosum)

Cette maladie virale plus fréquente dans l'enfance provoque une croissance de la peau de longueur de longue durée mais relativement inoffensive de papules de type perle. Les papules sont connues sous le nom de mollusques. Les gens qui vivent dans des zones surpeuplées sont plus sensibles à l'infection et se prospétent dans des conditions humides. Les dermatologues ont une grande variété d'options de traitement, mais aucun traitement n'est parfait et que le virus ne peut pas encore être tué. Les traitements pour molluscum contagiosum comprennent:
- Ablation chirurgicale
- Cryothérapie (congélation)
- Retrait au laser
- Élimination des produits chimiques
Teigne

Teigne is a well-known fungal infection that is common especially in school-age children. The namesake ring-shaped rash it causes can be treated using various topical creams as well as oral antifungal medicines in severe cases. Many ringworm medicines are available in the US without a prescription. If non-prescription methods don’t work tell your doctor.
Pied de l'athlète

Tout comme le pied de l'athlète de la teigne est causé par un champignon. En fait, plusieurs champignons peuvent provoquer cette infection brûlante qui démange. Il pousse généralement entre vos orteils mais peut se propager à votre talon et aux bords et semelles de vos pieds également. Le pied de l'athlète est très courant touchant de 15% à 25% de toutes les personnes à tout moment. Cette infection peut se propager à d'autres parties du corps et à d'autres personnes et de nombreuses personnes sont infectées sans le savoir. C'est une bonne idée de vérifier vos pieds, en particulier entre vos orteils - pour des signes de peau fissurée. Il existe plusieurs médicaments antifongiques utilisés pour traiter le pied et les allylamines topiques des athlètes comme la terbinafine semblent être plus cohérentes que les autres types.
Pouvez-vous prendre des antiacides avec prilosec
Parasites de la peau

Un parasite est-il à blâmer pour votre infection cutanée? Des parasites cutanés, y compris de minuscules créatures fouillantes comme la gale et les ankylostomes et d'autres qui se reproduisent sur votre peau comme les poux de tête. La peau irritée rouge démangeaisons est une réaction commune à un parasite de la peau. Si vous pensez que vous pouvez avoir des parasites cutanés, parlez à votre médecin ou à un dermatologue des shampooings de lotions ou d'autres produits médicamenteux pour secours.
Candidose (Infection à levures fongiques)
Votre corps hôte Candidose Levure naturellement dans votre intestin commençant peu de temps après votre première naissance. Beaucoup de gens l'ont aussi sur leur peau et vit souvent dans la gorge de la bouche et le vagin. Cela ne cause généralement aucun problème. Mais parfois, cette levure peut s'installer en tant qu'infection cutanée, en particulier dans les plis cutanés tels que les aisselles. Ces infections sont parfois difficiles à traiter comme de plus en plus Candidose Les infections sont résistantes aux médicaments antifongiques courants.
Infection à staphyle (staphyle d'or)

Les infections stapales sont courantes. Également appelé «Staph Golden» de 15% à 40% des personnes ont Staphylococcus aureus bactéries sur leur peau à tout moment. Mais votre système immunitaire le garde généralement sous contrôle. Si vous avez la peau sèche, vous pouvez être plus vulnérable car la peau sèche se casse facilement. Ces ruptures de peau donnent une entrée pratique aux bactéries stapales. Les infections peuvent être un signe de diabète mal contrôlé ou d'autres problèmes d'immunité, donc si vous les obtenez fréquemment ou sévèrement en informer votre médecin. Staph envahit parfois une plaie ouverte provoquant une infection des plaies. Et les mères allaitées devraient faire particulièrement attention aux infections des seins, car ces infections à staphylocoque peuvent être transmises aux enfants par le lait maternel. La staphylocoque est contagieuse et si elle entre dans votre circulation sanguine, cela peut provoquer une intoxication sanguine mortelle (septicémie). Gardez vos blessures propres et recouvertes de laver les mains fréquemment et d'éviter de partager des objets personnels comme des serviettes et des rasoirs.
Cinquième maladie (parvovirus humain)

Vous avez peut-être entendu parler des infections au parvovirus chez les animaux de compagnie, mais les humains ne peuvent pas l'attraper des animaux de compagnie. Cependant, le parvovirus B19 est un type qui se propage entre les humains. Les enfants sont plus susceptibles de contracter la cinquième maladie, une infection virale causée par le parvovirus B19. Il peut provoquer une éruption cutanée rouge sur le visage qui lui donne le surnom du «syndrome des joues giflé». Bien que la maladie soit généralement légère, elle peut causer de graves problèmes aux personnes atteintes de maladies drépanocytaires faibles et d'autres types d'anémie chronique. Les adultes qui le contractent peuvent également développer une arthrite.
Lèpre (maladie de Hansen)

La lèpre est une infection cutanée bactérienne à croissance très lente. Dans certains cas, il faut deux décennies avant l'infection de la lèpre provoque des symptômes. Les tissus corporels les plus susceptibles d'être affectés sont les nerfs des yeux de la peau et la muqueuse du nez. Depuis les temps anciens, la lèpre a infecté des gens. Avant récemment, les personnes qui ont développé une lèpre (également appelée maladie de Hansen) ont été ostracisées de amis et de famille de peur que leur infection bactérienne puisse se propager. Mais à la fin du 20e siècle, un remède connu sous le nom de thérapie multidrogue a émergé, ce qui tue le micro-organisme de la lèpre Mycobacterium leprae . Le traitement arrête également la propagation de la maladie permettant aux personnes atteintes de lèpre de fonctionner et de vivre entre autres en bonne santé.
Infections cutanées: Types Causes et symptômes
Sources: 
Images fournies par:
- TTSZ / Thinkstock
- Pobladurafcg / thinkstock
- Rank600 / Thinkstock
- Eraxion / Thinkstock
- SPL / source scientifique
- Images Scott Camazine / Getty
- Allan Harris / Images médicales
- Collection Watney / Images médicales
- Luis M. de la Maza / Medical Images
- Dabjola / Thinkstock
- ensemble / thinkstock
- Dr P. Marazzi / Science Science
- Alejandrophotography / Getty Images
- Dr P. Marazzi / Science Science
- Oeil de science / source scientifique
- action
- Gregory Moran M.D. gracieuseté de CDC.
- Medscape
- Département américain de la santé et des services sociaux
Références:
Quelle est la pilule d'hydrocodone la plus forte
- American Academy of Dermatology: les couches de vos galets de peau.
- BMJ Meilleures pratiques: folliculite: Résumé Molluscum Contagiosum: Résumé.
- BMJ Evidence clinique: le pied de l'athlète.
- CDC: Résistance antifongique dans l'herpès génital de Candida candidose - Fiche d'information du CDC 'maladie de Hansen (lèpre): Qu'est-ce que la maladie de Hansen? Methicillin-resistant Staphylococcus aureus (MRSA): Laboratory Testing Monitoring the impact of varicella vaccination' Necrotizing Fasciitis: A Rare Disease Especially for the Healthy Parvovirus B19 and Fifth Disease Ringworm 'Skin Infections.'
- Dermnet NZ: Péchons de tête «Candida» de la tête - codes et concepts de l'herpès simplex 'impétigo méthicillin staphylococcus aureus molluscum contagiosum antifonggal Principles de la pratique du derme et de la médication de la infectieuse du scabal de sous-édineur.
- Infectious Disease Society of America: Practice Lignes directrices pour le diagnostic et la gestion des infections cutanées et des tissus mous: mise à jour de 2014 par la Société des maladies infectieuses.
- Institut InformEdHealth.org pour la qualité et l'efficacité des soins de santé (IQWIG): Foot de l'athlète: Présentation 'Poullon: Présentation.
- John Hopkins Medicine: Infections parasites de la peau.
- Clinique Mayo: Molluscum Contagiosum Cellulilite folliculite furance et bardeaux de carbuncles.
- Fondation Nemours: teigne de la varicelle impétigo.
- Département de la santé de l'État de New York: cinquième maladie (érythème infectiosum parvovirus b19 infections).
- Brevets récents sur l'inflammation
- Stanford: Infections cutanées et tissus mous en milieu hospitalier.
- Qui: Léprosy.
Cet outil ne fournit pas de conseils médicaux. Voir des informations supplémentaires: 
Cet outil ne fournit pas de conseils médicaux. Il est destiné à des fins d'information générales uniquement et ne traite pas des circonstances individuelles. Il ne remplace pas le diagnostic ou le traitement professionnel des conseils médicaux et ne doit pas être invoqué pour prendre des décisions concernant votre santé. N'ignorez jamais les conseils médicaux professionnels dans la recherche de traitement à cause de quelque chose que vous avez lu sur le site RXList. Si vous pensez avoir une urgence médicale, appelez immédiatement votre médecin ou composez le 911.
© 1996-2025 WebMD LLC . Tous droits réservés.
